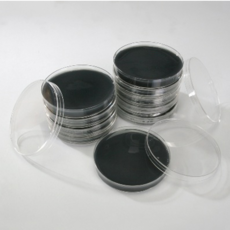
세균배양배지

좋은 하루 보내셨나요? (^.^)
타칭 IT러버인 별다섯 인사드려요^^
오늘은
세균배양배지에 관해 리뷰해드릴께요.
【세균배양배지 강추꿀템 간단 리뷰정리】
< 포스팅 목차 >
① 신문기사 ② 최근영상 ③ 판매순위
☞ 세균배양배지 관련 주간 뉴스근황 확인하기 ☜
충북농기원 표고버섯 배지 베트남 수출길
물방울 안맺히는 깨끗한 정수기...학생 발명왕 총리상 수상
경기농기원, 버섯 재배시설 오염도 측정 ‘자가진단 배지키트’ 농가 공급
☞ 관련 영상 ☜
☞ 선호랭킹 리스트 ☜
|

|
1위
[MEDION]메디온 식품공전 표준한천배지 생배지 일반세균 배양배지 Plate Count Agar(PCA) 20plate
25,900원
[ 제품 및 후기보기 ]
|
|

|
5위
사이언스몰 일반세균 + 곰팡이균 배지 만들기 10인용 화학실험세트, 1세트
12,200원
[ 제품 및 후기보기 ]
|
|

|
7위
세균배양배지 만들기키트 10인용(일반세균 대장균 황색포도상구균 곰팡이균 선택)
15,200원
[ 제품 및 후기보기 ]
|
|

|
8위
[MEDION]메디온 식품공전 보통한천배지 생배지 Nutrient Agar(NA) 20plate
29,800원
[ 제품 및 후기보기 ]
|
|

|
11위
오피스안 TSA Media Plate SN 부유세균배양배지 낙하세균배양배지 개별상품
5,560원
[ 제품 및 후기보기 ]
|
|

|
14위
디에스스토리 세균배양배지 만들기 세트 10인용-황색포도상구균(MSA) 과학실험
15,400원
[ 제품 및 후기보기 ]
|
|

|
16위
오피스안 세균배양배지(대장균용배양배지) 60mm SN221 pack 10ea
50,090원
[ 제품 및 후기보기 ]
|
|
|
17위
오피스안 세균배양배지(살모넬라균배양배지 이질균배양배지) 60mm SN224 개별상품
5,560원
[ 제품 및 후기보기 ]
|
|

|
20위
오피스안 세균배양배지(비브리오배양배지) 60mm SN223 pack 10ea
50,090원
[ 제품 및 후기보기 ]
|
인플루언서들이 추천할 만한 세균배양배지 상품들의 목록을 만들어보았습니다.
제품정보, 가격 등은 항상 변동이 될 수 있다는 점 꼭 참고하시구요.
앞으로도 좋은 제품을 공유하기 위해 노력할께요~
Have a good day ^^
오늘 포스팅은 광고활동으로서 일정수익금을 수령받을수 있어요 .
|